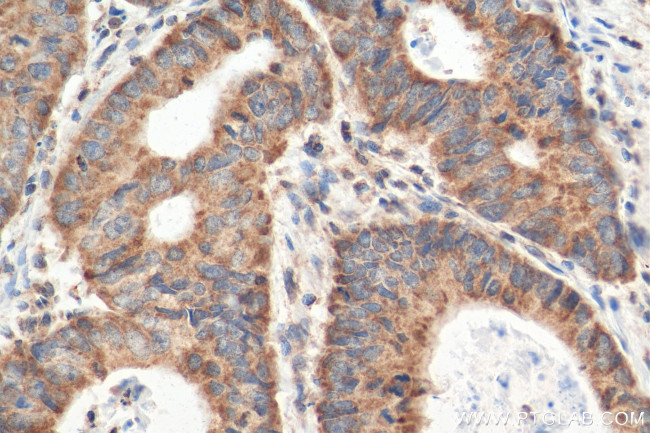
CCL28 Antibody in Immunohistochemistry (Paraffin) (IHC (P))
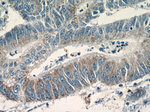
CCL28 Antibody in Immunohistochemistry (Paraffin) (IHC (P))

Search
Proteintech
CCL28 Polyclonal Antibody
{{$productOrderCtrl.translations['antibody.pdp.commerceCard.promotion.promotions']}}
{{$productOrderCtrl.translations['antibody.pdp.commerceCard.promotion.viewpromo']}}
{{$productOrderCtrl.translations['antibody.pdp.commerceCard.promotion.promocode']}}: {{promo.promoCode}} {{promo.promoTitle}} {{promo.promoDescription}}. {{$productOrderCtrl.translations['antibody.pdp.commerceCard.promotion.learnmore']}}
产品信息
18214-1-AP
种属反应
已发表种属
宿主/亚型
分类
类型
抗原
偶联物
形式
浓度
规格
纯化类型
保存液
内含物
保存条件
运输条件
产品详细信息
Immunogen sequence: MQQRGLAIV ALAVCAALHA SEAILPIASS CCTEVSHHIS RRLLERVNMC RIQRADGDCD LAAVILHVKR RRICVSPHNH TVKQWMKVQA AKKNGKGNVC HRKKHHGKRN SNRAHQGKHE TYGHKTPY (1-127 aa encoded by BC069532)
靶标信息
MEC is a secreted CC chemokine expressed primarily by epithelial cells of the bronchioles, salivary gland, mammary gland and colon. MEC signals through the CCR10 receptor, and chemoattracts resting CD4, CD8 T-cells and eosinophils. MEC contains six cysteines, including the four highly conserved cysteine residues present in CC chemokines.
仅用于科研。不用于诊断过程。未经明确授权不得转售。
生物信息学
蛋白别名: C-C motif chemokine 28; CC chemokine CCL28; CCK 1; CCK1 protein; CCL 28; CCL28chi; chemokine; chemokine (C-C motif) ligand 28; MEC; Mucosae-associated epithelial chemokine; Protein CCK1; small inducible cytokine A28; small inducible cytokine subfamily A (Cys-Cys), member 28; Small-inducible cytokine A28; unnamed protein product
基因别名: CCK1; CCL28; MEC; SCYA28
UniProt ID: (Human) Q9NRJ3, (Mouse) Q9JIL2
Entrez Gene ID: (Human) 56477, (Mouse) 56838